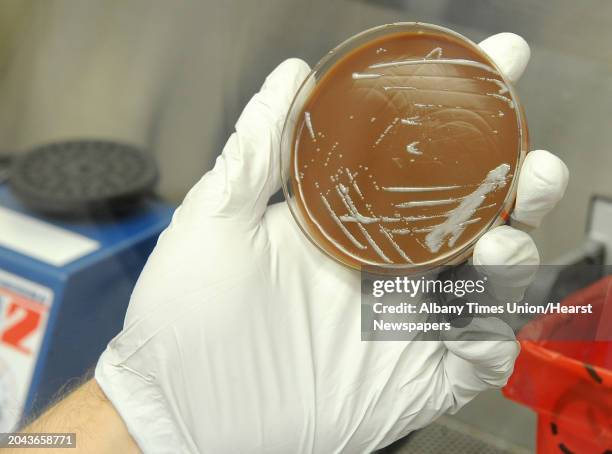
PhD. Student Brian Franz holds Francisella Tularensis bacteria growth on a chocolate agar plate under a hood in a lab where research is done on...

16 Francisella Tularensis Stock Photos & High-Res Pictures
View francisella tularensis videos
Browse 16Ìý²¹³Ü³Ù³ó±ð²Ô³Ù¾±³¦ francisella tularensis stock photos, high-res images, and pictures, or explore additional yersinia pestisÌý´Ç°ùÌýclostridium botulinum stock images to find the right photo at the right size and resolution for your project.

of1